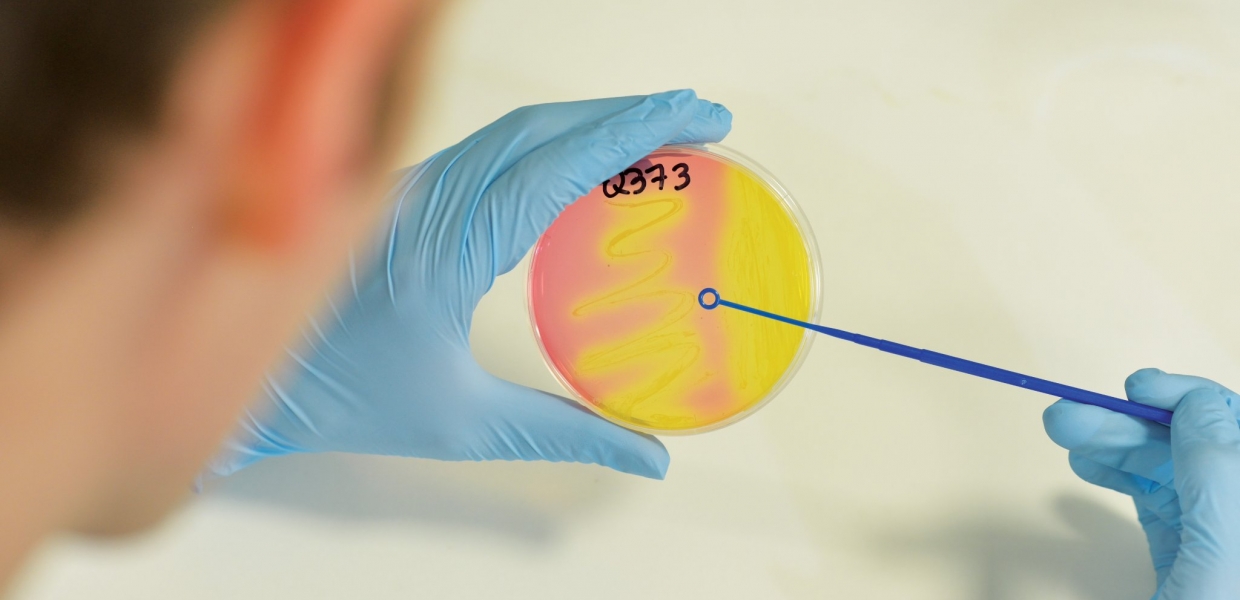

The Centre for Experimental Medicine at Queen’s University is a brand new, state of the art research facility that accommodates over 200 research staff. These researchers are committed to improving the lives of patients, and focus their efforts around four main themes: eye diseases, diabetes and vascular disease, infectious diseases and respiratory illness.
Join us for a showcase event to gain first-hand insights into disease focused research, with demonstrations of basic laboratory experiments, patient-based research and clinical trials. Several strands of research will be highlighted in the form of short talks, interactive stands and hands on stalls.
British Heart Foundation Northern Ireland (BHF NI) will have an interactive exhibition on the past 50 years of heart research breakthroughs. BHF NI has invested £3.1 million into research at Queen’s University. The charity is the biggest funder of cardiovascular research in the UK, helping scientists to undertake pioneering research into many different heart conditions, their diagnosis and treatment.
Tours of the building will allow visitors to appreciate the work of Queen’s University to disease focused and patient based research.
Directions and Parking - Turn onto Jubilee road from the Lisburn Road and then take the first left into the MBC car park. Parking is free and volunteers will be available to direct you to the event.